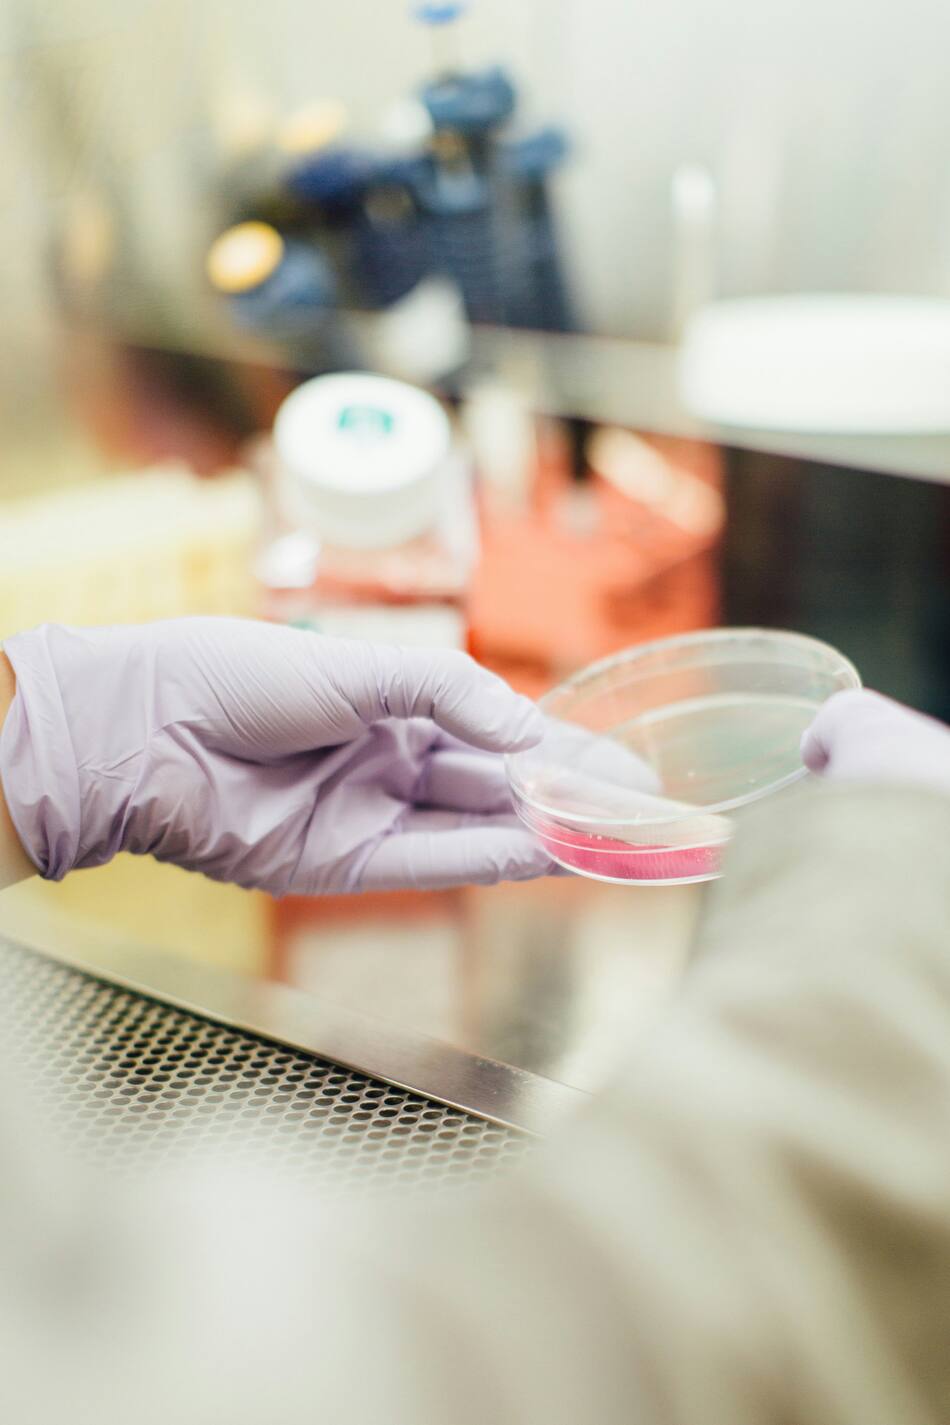

Inmunoterapia: un nuevo anticuerpo conecta células claves para combatir el cáncer
El Instituto Weizmann desarrolló este tratamiento basado en la comunicación cruzada entre diferentes células inmunitarias para tratar tumores y enfermedades autoinmunes.

En la carrera de la lucha contra el cáncer, la gran promesa de la inmunoterapia es punta de lanza debido a que se trata de una nueva generación de tratamientos que aprovechan el propio sistema inmunológico del cuerpo para poder combatir la enfermedad.
Mediante un estudio publicado en Cell, los investigadores del Instituto de Ciencias Weizmann presentaron un anticuerpo desarrollado recientemente que conecta las células T con las células dendríticas, creando una poderosa respuesta inmunitaria contra los tumores de origen canceroso.

Una nueva inmunoterapia da esperanza para combatir el cáncer. Fuente: Unsplash
Esta investigación abrió una nueva puerta a la inmunoterapia, ya que conecta varias células del sistema inmunitario para crear un equipo de combate de primera para derrotar al cáncer y otras enfermedades.
De hecho, una de las inmunoterapias más destacadas utiliza anticuerpos que bloquean el PD-1m y receptor regulador que se encuentra en la superficie de las células T y cuando éste se expresa, una proteína muy extendida en el entorno tumoral puede unirse a él, provocando que las células T entren en un estado conocido como agotamiento.
Los anticuerpos PD-1 impiden que esta proteína se una a las células T y las repriman, pero muchos pacientes con cáncer no responden a este tratamiento; en muchos otros, la eficacia es de corta duración.

tratamiento contra el cáncer. Fuente: Unsplash
Los investigadores del Dr. Rony Dahan y el Prof. Ido Amit en el Instituto Weizmann lograron realizar avances significativos en la inmunoterapia contra el cáncer, revelando que las células dendríticas son esenciales para activar las células T en la lucha contra los tumores.
Para poder demostrarlo, los científicos utilizaron tecnologías avanzadas, analizaron casi 130,000 células T de modelos de cáncer en ratones tratados con anticuerpos PD-1, y descubrieron que la interacción entre las células T y una población rara de células dendríticas era crucial para la efectividad del tratamiento.
Ante esta necesidad, desarrollaron un nuevo anticuerpo llamado BiCE (Bispecific DC-T Cell Engager), que no solo activa las células T al inhibir el receptor PD-1, sino que también recluta las células dendríticas necesarias para potenciar la respuesta inmune.

El tratamiento dio resultado en ratones con cáncer. Fuente: Unsplah.
Inmunoterapia: el nuevo tratamiento que daría esperanza a enfermedades incurables
Los experimentos realizados por los científicos mostraron que BiCE aumenta el número de interacciones entre células T y dendríticas en el tumor y en los ganglios linfáticos, lo que activa una robusta respuesta inmune contra el cáncer.
De hecho, la eficacia de este nuevo tratamiento fue probado en varios modelos de cáncer en ratones, incluidos cáncer agresivos de mama, pulmón y piel, ya que con los nuevos anticuerpos reducen significativamente la tasa de crecimiento.
Aunque algunos tumores, como el cáncer de mama, no respondieron como esperaban los científicos, la combinación de BiCE con otros tratamientos que estimulan las células dendríticas mostró resultados prometedores. Además, BiCE demostró que es posible prevenir la recurrencia del cáncer tras la extirpación del tumor primario, sugiriendo que genera una respuesta inmune sistémica efectiva.
tratamiento contra el cáncer. Fuente: Unsplash
Este enfoque innovador en la inmunoterapia no solo se centra en el cáncer, sino que también tiene potencial para tratar enfermedades autoinmunes al permitir una modulación específica de la respuesta inmune, lo que podría transformar la forma en que se manejan diversas patologías.
Yeda Research and Development, responsable de la comercialización de la propiedad intelectual de los científicos del Instituto Weizmann, ya hizo la presentación oficial de la solicitud de patente y está trabajando para desarrollar un tratamiento innovador basado en el anticuerpo de Weizmann.

















